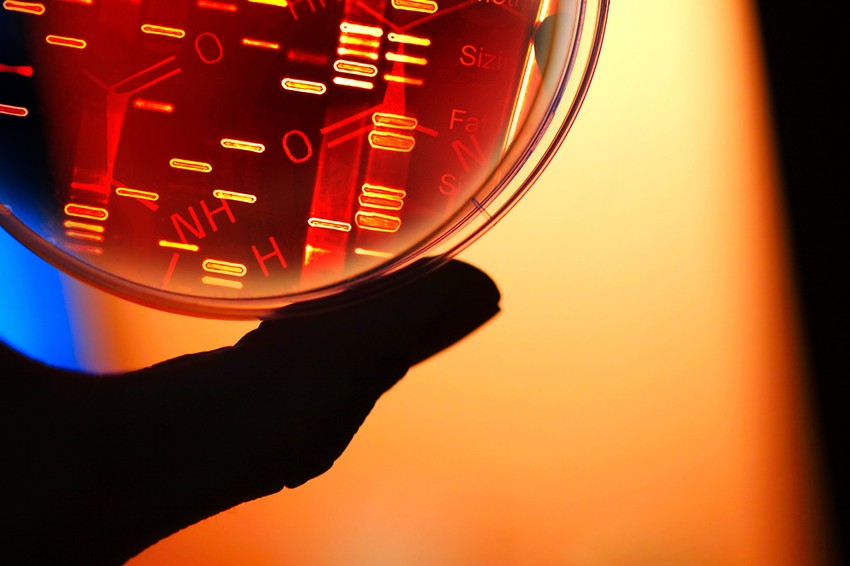
Milyen jelek utalnak daganatra? Mutatjuk!

Ne csak azért vegye ki, mert így felmelegszik benne a víz.
Míg a gyártási folyamatból származó egyes vegyszer maradványok az összes műanyag edényt beszennyezik és a benne lévő élelmiszerekbe vagy italokba kerülhetnek, a PET műanyag vizes palackok viszonylag alacsony mennyiségben tartalmazzák ezeket a mikroműanyagokat, így viszonylag biztonságosan használhatók vízhez.
Itt a probléma
Ezeket a palackokat nem arra szánják, hogy napfénynek tegyék ki, vagy forró autóban tárolják őket.
Az UV-sugárzás képes ugyanis megszakítani a kémiai kötéseket a műanyagokban, (beleértve a PET palackokat is) is és ez a műanyag gyors lebomlását okozza. A Plastics Today egyik cikke szerint: "A PET érzékeny az UV-fényre, különösen a magas hőmérsékletre. Ez a folyamat akkor is megtörténik, amikor az emberek a kulacsukat az autójukban, vagy maguk mellett tartják a strandon."
A Recycle Magazine cikke szerint: „Az adatok egyértelműen azt mutatják, hogy az ultraibolya sugárzásnak való kitettség nagyon káros a PET-anyagra. Más szóval, a napfény és a hő lebontja a műanyagot, és rengeteg vegyszert termel."
Mi a baj azzal, hogy a műanyagokból származó vegyszerek lebomlanak?
Az Endocrine Society szerint : „a műanyagok veszélyes vegyi anyagokat tartalmaznak, beleértve az endokrin rendszert károsító vegyi anyagokat (EDC), amelyek veszélyeztetik az emberi egészséget. "
Az EDC-k olyan vegyi anyagok, amelyek megzavarják a szervezet hormonrendszerét, és rákot, cukorbetegséget, meddőséget és neurológiai károsodásokat okozhatnak. A jelentés számos bizonyítékot ír le, amelyek alátámasztják a műanyagokban található mérgező kémiai adalékanyagok és az endokrin rendszerre gyakorolt speciális egészségügyi hatások közötti közvetlen ok-okozati összefüggést.
A PET-csomagolások fejlesztésére szakosodott Plastic Technologies által végzett kutatás megállapította, hogy a palackok újrahasznosítás előtti ultraibolya sugárzásnak való kitettsége komoly hatással van a következő generációs, újrahasznosított (rPET-) palackok fizikai tulajdonságaira és vizuális jellemzőire.
Az Ecology Center 2022-es jelentésében a következőket írja: „Partnereink a Defend Our Healthnél húsz népszerű, műanyag palackos csomagolású italt teszteltek, és minden palackban antimont, rákkeltő műanyag vegyi anyagot találtak. A vizsgált italok 40 százaléka magasabb antimonszintet mutatott az ivóvízre vonatkozó közegészségügyi célértéknél.”
Az antimon, amely mérgező a májra és a szívre, a PET műanyag előállítása során a végső reakció felgyorsítására szolgál.
Az Ecology Center 2022-es jelentésében a következőket írja: „Partnereink a Defend Our Healthnél húsz népszerű, műanyag palackos csomagolású italt teszteltek, és minden palackban antimont, rákkeltő műanyag vegyi anyagot találtak. A vizsgált italok 40 százaléka magasabb antimonszintet mutatott az ivóvízre vonatkozó közegészségügyi célértéknél.” Az antimon, amely mérgező a májra és a szívre, a PET műanyag előállítása során a végső reakció felgyorsítására szolgál.
"A műanyag azonban túlságosan nagy piaci tényező ahhoz, hogy a folyamatok megváltozzanak" – hívja fel a figyelmet a Food Safety News cikke. 2021-ben 390 millió tonna műanyagot állítottak elő, és ez a mennyiség minden kimutatott egészségügyi veszély ellenére dinamikusan emelkedik.
Egyes szakértők szerint a problémára a műanyag újrahasznosítása sem elég hatékony megoldás. Alternatív, egészségügyi és környezetvédelmi szempontból az alumíniumdobozok lehetnek az egyetlen olyan helyettesítő eszközök, amelyek megtörhetik a műanyag károkozását.
Összegezve
- Nem szabad napfénynek vagy magas hőmérsékletnek kitenni a PET palackokat, mert az UV-sugárzás gyors lebomlást okozhat.
- A műanyagok veszélyes vegyi anyagokat, az endokrin rendszert károsító EDC-ket tartalmazhatnak, amelyek számos egészségügyi problémát okozhatnak.
- Az alumíniumdobozok remek alternatívák lehetnek.
Rosszindulatú daganatos elváltozás: 9 tünet, ami már korán jelezheti
Kövesse az Egészségkalauz cikkeit a Google Hírek-ben, a Facebook-on, az Instagramon vagy a X-en,Tiktok-on is!